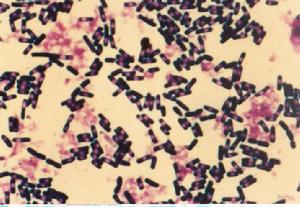
非感染性心內膜炎

介紹
 心內膜炎
心內膜炎1.贅疣性血栓性心內膜炎贅疣性血栓性心內膜炎(endocarditisverrucothrombotica)以血液凝固性過高和(或)消耗性血液凝固病為基礎,例如可因腫瘤崩解產物(如腺癌的粘液)、休克、內毒素血症和惡病質而引起。因此,相應地又稱為腫瘤心內膜炎、休克心內膜炎及消耗性心內膜炎。大多數侵犯左心瓣膜,心房內膜偶爾亦被累及。在心瓣膜閉鎖緣形成1mm大或以上的血小板血栓,有時呈息肉狀。
2.Libman-Sacks血栓性心內膜炎(Libman-Sacksthromboticendocarditis)見於系統性紅斑狼瘡。心瓣膜(主要見於二尖瓣和三尖瓣)閉鎖緣可見一些2~4mm大的粗糙疣狀血栓沉積物。
3.Lбffler纖維增生性壁性心內膜炎(endocarditisparietalisfibroplasticaLöffler)頗為少見,幾乎只見於男性。特點雖幾乎只侵犯心壁內膜,好發於左心室並累及心尖區,但從不侵犯瓣膜和腱索內膜。病因未明,屬感染變態反應範疇。早期可見嗜酸性心內膜炎、心肌炎和心包炎,伴有心肌壞死及心壁內動脈炎。壞死物被富含嗜酸性粒細胞的肉芽組織所清除吸收,最後形成瘢痕。被累心內膜可呈白色腱樣外觀,可並發附壁血栓。心包炎後期可發生纖維化、鈣化而形成所謂鎧甲心。
病因學
 非感染性心內膜炎
非感染性心內膜炎非感染性心內膜炎的贅生物臨床上難以檢出,但可成為循環中微生物停留的核心,產生栓子或損害瓣膜功能。導管通過右心可損害三尖瓣和肺動脈瓣,使血小板和纖維蛋白接觸損傷的部位.在人類導管導致心內膜炎的發生率較動物試驗為低。
在系統性紅斑狼瘡(SLE)病人沿著瓣葉閉合緣可產生易碎的血小板和纖維蛋白組成的贅生物.屍解時,死於活動性SLE者40%有一個或多個瓣膜病灶。這種稱為Libman-Sack病灶通常不伴有明顯的瓣膜狹窄或反流,雖然聽診可聞及輕度反流性雜音。抗磷脂綜合徵病人(狼瘡抗凝,反覆性靜脈血栓形成,腦卒中,自發性流產,網狀青斑)亦可發生無菌性心內膜贅生物和體循環栓塞。
較大的瓣膜血栓性病灶脫落後可致腦,腎,脾,腸系膜,肢體和冠狀動脈明顯的栓塞,可見於慢性消耗性疾病;瀰漫性血管內凝血(DIC);肺,胃,胰能分泌粘液mucin的轉移性癌腫;以及慢性感染(如結核,肺炎,骨髓炎).這些贅生物有附著於受風濕熱損害的異常心臟瓣膜或先心病的傾向,以二尖瓣最常見,其次為主動脈瓣以及兩者之混合。
臨床表現
 瘤細胞栓子
瘤細胞栓子臨床表現
非感染性心內膜炎多見於中老年≥50歲者占79.2%但可見於任何年齡組非感染性心內膜炎缺乏特異性的症狀和體徵。聽診對診斷非感染性心內膜炎幫助不大,僅1/3病例可出現心臟雜音,多位於胸骨下緣偶向心尖傳導雜音性質柔和。半數病例可發生栓塞症狀,如腦栓塞可出現偏癱冠脈栓塞可引起心肌缺血或心肌梗死腎動脈栓塞可產生腎絞痛等等,但由於非細菌性血栓性心內膜炎的贅生物較小因而栓子微小,故極少引起大動脈和中等動脈栓塞多為小動脈栓塞,故多數病例雖有栓塞而無症狀,因此不少病例生前未能診斷。
細菌
細菌併發症
栓塞:因為非細菌性血栓性心內膜炎的非細菌性贅生物較脆,病變也表淺一旦脫落可產生動脈栓塞。如腦栓塞可出現偏癱;冠狀動脈栓塞可引起心肌缺血或心肌梗死;腎動脈栓塞可產生腎絞痛等。但由於非感染性心內膜炎中非細菌性贅生物的較小,所形成的血栓也較小使多數病例雖有血栓但無明顯臨床症狀,造成生前的漏診。
診斷
Mcray對臨床診斷非細菌性血栓性心內膜炎提出三聯症:
1.已知可發生非細菌性血栓性心內膜炎的疾病。
2.心臟出現雜音或新雜音或原有雜音發生變化。
3.身體有多發性栓塞
此外,靜脈血栓症DIC實驗室診斷以及多次血培養陰性,均有助於非細菌性血栓性心內膜炎的診斷。若結合UCG發現贅生物則更有利於診斷。
鑑別診斷
非感染性心內膜炎應與急性感染性心內膜炎、亞急性感染性心內膜炎、Loffer心內膜炎、Libman-Sacks心內膜炎等疾病相鑑別。
病因治療
症狀描述
 風濕性心內膜炎
風濕性心內膜炎病因
尚未闡明。Gross等認為風濕性瓣膜病是非細菌性血栓性心內膜炎的重要病因。Allen和Sirota則認為變態反應和維生素C缺乏是非感染性心內膜炎的易發因素。Williams認為變態反應和循環免疫複合物是瓣膜損害的免疫學基礎。
藥療方案
由於原先存在疾病的嚴重性,非感染性心內膜炎預後惡劣。非感染性心內膜炎的治療包括用肝素或華法林抗凝,雖然抗凝治療的效果尚未評估。若有可能應治療原先存在的疾病。
1.治療原發病非感染性心內膜炎的發生與腫瘤、DIC有關,因此關鍵治療原發病。
2.抗凝治療靜脈注射肝素,阻止纖維蛋白和血小板在瓣膜上沉積和聚集,對防止血栓發生有一定療效。華法林(warfarin)無效。至於抗血小板藥物如阿司匹林、雙嘧達莫(潘生丁)和磺吡酮(苯磺唑酮)等的價值尚待進一步研究。
預後預防
 單核細胞
單核細胞因其原發疾病較嚴重,非感染性心內膜炎預後較差。
預防:
積極預防和治療原發疾病對年老體弱、有慢性消耗性疾病惡性腫瘤等病的患者要仔細臨床觀察早期發現、早期治療。
非感染性瓣膜贅生物(non-infectivevalvularvegetation,NIVV)除NBTE外常見的尚有以下幾種情況:
1.系統性紅斑狼瘡(SLE)早在1924年Libman和Sacks首先報導SLE可在心瓣膜產生贅生物來超聲心動圖證實SLE患者中有18%~40%合併NIVV稱為Libman-Sacks心內膜炎其中二尖瓣最易受累其次為主動脈瓣,贅生物病理特點大小一般為3~5mm呈灰色或粉紅色,豌豆狀或扁平狀常與心內膜粘連在一起,可伴血栓鏡下有纖維蛋白、纖維組織形成可有血小板或血栓黏附伴少量單核細胞浸潤。
(1)臨床表現:主要表現為SLE的症狀少數病例可出現二尖瓣關閉不全的收縮期雜音若累及主動脈瓣可產生主動脈瓣反流性雜音偶爾贅生物脫落也可引起體動脈栓塞的相應徵象。一組50例SLE屍檢發現,有10例出現腦梗死,其中5例與Libman-Sacks心內膜炎贅生物脫落阻塞有關超聲心動圖尤其是食管超聲心動圖檢查較易發現瓣膜上的贅生物有確診價值但有時難以與SLE合併SIE作鑑別。若血漿中磷脂水平增高且有抗原抗體反應者多系SLE並發Libman-Sacks心內膜炎。
(2)主要治療原發病,較大的贅生物有人主張採用抗凝治療,常用的有華法林、醋硝香豆素但需考慮出血危險性,其療效尚待進一步證實。若因累及瓣膜導致嚴重關閉不全者則需外科手術治療,但這種情況少見。
2.原發性抗磷脂綜合徵(primaryantiphospholipidesyndromepaps)本綜合徵與血清中存在磷脂抗體有關患者常有反覆流產血小板減少和反覆動靜脈栓塞為特徵。若患者凝血酶原時間延長而加入正常血漿仍不能糾正時應考慮PAPS的可能,綜合徵血磷脂抗體陽性,對診斷有較大價值,雖SLE患者血清磷脂抗體也可陽性但同時有抗雙鏈DNA抗體陽性抗Sm抗體和抗核抗體陽性以資鑑別而PAPS血清心脂抗體陽性明顯增高非感染性心內膜炎瓣膜贅生物主要依靠超聲心動圖檢出一般贅生物大小為2~6mm。非感染性心內膜炎極少引起瓣膜功能障礙。
治療:與SLE並Libman-Sacks心內膜炎相似。
觀察
肉眼觀察,非細菌性血栓性心內膜炎,非感染性心內膜炎
 惡性腫瘤
惡性腫瘤肉眼觀察,非細菌性血栓性心內膜炎
這又是一個位於最右方尖端的消耗性贅生物,這類贅生物的大小雖然很少超過0.5厘米,但是非常容易形成栓塞。
顯微鏡觀察,非細菌性血栓性心內膜炎
可見瓣膜在左邊,一個不明顯的贅生物在右邊。贅生物由纖維蛋白和血小板組成,所以呈淡紅色。它像牛皮紙袋一樣可發生多種變形。這不明顯的贅生物是非感染性心內膜炎的典型表現形式。
類型
 非感染性心內膜炎
非感染性心內膜炎1.贅疣性血栓性心內膜炎贅疣性血栓性心內膜炎(endocarditisverrucothrombotica)以血液凝固性過高和(或)消耗性血液凝固病為基礎,例如可因腫瘤崩解產物(如腺癌的粘液)、休克、內毒素血症和惡病質而引起。因此,相應地又稱為腫瘤心內膜炎、休克心內膜炎及消耗性心內膜炎。大多數侵犯左心瓣膜,心房內膜偶爾亦被累及。在心瓣膜閉鎖緣形成1mm大或以上的血小板血栓,有時呈息肉狀。
2.Libman-Sacks血栓性心內膜炎(Libman-Sacksthromboticendocarditis)見於系統性紅斑狼瘡。心瓣膜(主要見於二尖瓣和三尖瓣)閉鎖緣可見一些2~4mm大的粗糙疣狀血栓沉積物。
3.Lбffler纖維增生性壁性心內膜炎(endocarditisparietalisfibroplasticaLöffler)頗為少見,幾乎只見於男性。特點雖幾乎只侵犯心壁內膜,好發於左心室並累及心尖區,但從不侵犯瓣膜和腱索內膜。病因未明,屬感染變態反應範疇。早期可見嗜酸性心內膜炎、心肌炎和心包炎,伴有心肌壞死及心壁內動脈炎。壞死物被富含嗜酸性粒細胞的肉芽組織所清除吸收,最後形成瘢痕。被累心內膜可呈白色腱樣外觀,可並發附壁血栓。心包炎後期可發生纖維化、鈣化而形成所謂鎧甲心。
對比
感染性心內膜炎(infectiveendocarditis)指因細菌、真菌和其它微生物(如病毒、立克次體、衣原體、螺鏇體等)直接感染而產生心瓣膜或心室壁內膜的炎症,有別於由於風濕熱、類風濕、系統性紅斑性狼瘡等所致的非感染性心內膜炎。過去將非感染性心內膜炎稱為細菌性心內膜炎(bacterialendocarditis),由於不夠全面現已不沿用。感染性心內膜炎典型的臨床表現,有發熱、雜音、貧血、栓塞、皮膚病損、脾腫大和血培養陽性等。
